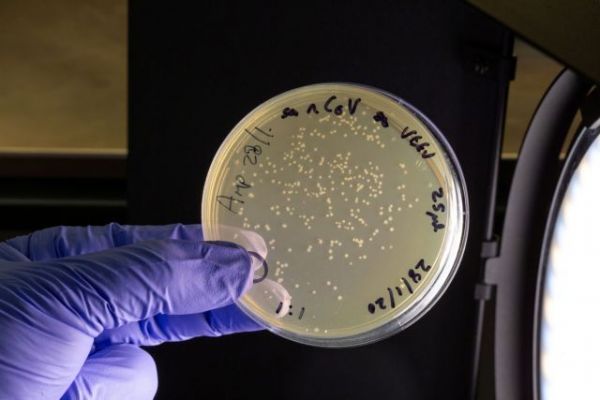

Ο καθηγητής Ρόμπιν Σάτοκ θα ήθελε να έχει λίγο περισσότερο χρόνο για να αναπτύξει την επαναστατική του προσέγγιση για τα εμβόλια. Είναι σίγουρος ότι όχι μόνο θα καταστεί σωτήρια στο πλαίσιο της πανδημίας του κοροναϊού, αλλά και θα αποτελέσει τον νέο τρόπο ανάπτυξης εμβολίων εντός των επόμενων πέντε ετών.
Η ομάδα του στο Imperial College εργάστηκε για την ανάπτυξη εμβολίων για τον Έμπολα και για τον πυρετό Λάσα χρησιμοποιώντας αυτή τη νέα τεχνολογία, όμως δεν είχα φτάσει ακόμη στο στάδιο των δοκιμών σε ανθρώπους όταν ο κοροναϊός ξεκίνησε να σκοτώνει χιλιάδες άτομα στην Ουχάν της Κίνας.
Τα δεδομένα από δοκιμές σε ζώα τους έδειχναν ότι βρίσκονται σε καλό δρόμο. Όμως ο κοροναϊός είναι εκείνος που θα αποδείξει αν η προσέγγισή τους, την οποία αποκαλούν αυτό-ενισχυόμενο RNA είναι όντως επαναστατική.
Φροντίζει να μην υπόσχεται θαύματα, όμως είναι ξεκάθαρο ότι πιστεύει πως η ομάδα του θα τα καταφέρει καλύτερα από τους πάνω από 120 ανταγωνιστές της στην προσπάθεια ανάπτυξης εμβολίου για τον κοροναϊό.
«Φυσικά, αλλιώς δεν θα το προσπαθούσα», δήλωσε ο ίδιος στον Guardian.

«Είμαι συγκρατημένα αισιόδοξος ότι θα είναι εξίσου ή περισσότερο αποτελεσματικό από τα υπόλοιπα, αφού προκαλεί καλή απόκριση του ανοσοποιητικού στα μοντέλα σε ζώα. Εκτιμάμε ότι θα έχει αντίστοιχα αποτελέσματα και σε ανθρώπους, ενώ θα είναι και πολύ ασφαλές, καθώς χρησιμοποιούμε πολύ χαμηλές δόσεις», δηλώνει στον Guardian.
«Αυτό που δεν ξέρουμε είναι ποιο επίπεδο ανοσίας απαιτείται για να προλάβουμε τις λοιμώξεις. Αν είναι χαμηλό, το πιθανότερο είναι πως η πλειοψηφία των εμβολίων που αναπτύσσονται θα είναι αποτελεσματικά. Και αυτό θα είναι φανταστικό για τον πλανήτη».
«Αν χρειαζόμαστε ένα σχετικά υψηλό επίπεδο απόκρισης του ανοσοποιητικού, ίσως δούμε ορισμένα εμβόλια να τα καταφέρνουν καλύτερα από τα υπόλοιπα. Ελπίζω ότι το δικό μας θα ανήκει στα επιτυχή, όμως δεν υπάρχουν εγγυήσεις πριν δούμε τι δείχνουν τα δεδομένα».

Μια επαναστατική τεχνολογία
Το εμβόλιο του Imperial στηρίζεται σε τμήματα του γενετικού κώδικα του ιού αντί για τμήματα του ίδιου του ιού. Ο κώδικας εισάγεται στους μυς του χεριού εντός σταγονιδίων λίπους, το οποίο στη συνέχεια κατασκευάζει την περίφημη «κορώνα» του ιού. Έτσι, το ανοσοποιητικό σύστημα αναλαμβάνει δράση, παράγοντας αντισώματα για να τον καταπολεμήσει και – αν όλα πάνε καλά – δημιουργώντας μια ανάμνηση του ιού ως εχθρού που πρέπει να απωθηθεί σε περίπτωση πραγματικής λοίμωξης.
Εμβόλιο για όλους
Στόχος του Σάτοκ είναι ένα εμβόλιο που θα διατεθεί σε όλα τα δισεκατομμύρια των ανθρώπων του πλανήτη, ανεξάρτητα από το ΑΕΠ της χώρας τους. Κατά τη γνώμη του, αυτή είναι και η ομορφιά της προσέγγισής του: Είναι πολύ ασφαλής, χρησιμοποιεί ελάχιστα υλικά και μπορεί να παραχθεί πολύ γρήγορα σε μεγάλες ποσότητες.
Και πιστεύει ότι θα είναι πολύ φθηνό – μόλις 2 με 3 λίρες Αγγλίας ανά δόση. Πρόκειται για ψίχουλα, όταν μιλάμε για ένα ολοκαίνουργιο εμβόλιο. Συγκριτικά, τα εμβόλια για τον HPV κοστίζουν εκατοντάδες ευρώ.
Το Imperial έχει την υποστήριξη της Morningside Ventures που ανήκει στην οικογένεια Τσαν από το Χονγκ Κονγκ, και έχει συστήσει μια κοινωνική επιχείρηση με την επωνυμία VanEquity Global Health με σκοπό την ισότιμη διανομή του εμβολίου σε όλο τον κόσμο. Σκοπεύει να το παραχωρήσει δωρεάν στις φτωχές χώρες, πιθανώς αυξάνοντας τις τιμές για τις πλουσιότερες.
Αφελής η ιδέα ότι αρκεί ένα εμβόλιο
Αν πρόκειται για αγώνα δρόμου, το Imperial δεν πρόκειται να τον κερδίσει. «Δεν θα είμαστε πρώτοι, εκτός αν άλλοι αποτύχουν», εξηγεί. Ο λόγος που αυτό ενδέχεται να έχει σημασία, είναι το ότι όλη η ζήτηση και η χρηματοδότηση θα εστιαστούν στο πρώτο εμβόλιο που θα κριθεί αποτελεσματικό. Όμως θα υπάρχουν ζητήματα κόστους και όγκου παραγωγής.
Τα εμβόλια που αναπτύσσονται στις ΗΠΑ αναμένεται να μην βγουν από τα σύνορά της, καθώς η κυβέρνηση Τραμπ τονίζει ότι κάθε δόση που παρασκευάζεται πρέπει να διατεθεί πρώτα για τη σωτηρία της Αμερικής. «Υποπτεύομαι ότι αν είναι αποτελεσματικά, θα χρειαστεί τόση δουλειά για την κάλυψη των αναγκών των ΗΠΑ που πάντα θα υπάρχουν περιοχές του πλανήτη χωρίς πρόσβαση σε αυτά», προειδοποιεί ο Σάτοκ. «Η ιδέα ότι ένα μόνο εμβόλιο θα διατεθεί έγκαιρα σε όλο τον κόσμο είναι, κατά τη γνώμη μου, αφελής».
Συνδυασμός εμβολίων;
Κάθε εμβόλιο που αναπτύσσεται λειτουργεί με διαφορετικό τρόπο, ενώ δεν αποκλείεται οι υγειονομικές αρχές να καταλήξουν να προτείνουν συνδυαστική χρήση κάποιων εξ αυτών. Ορισμένα ενδέχεται να παρέχουν επαρκή ανοσία σε πρώτο χρόνο, όμως να μην μπορούν να επαναληφθούν όταν η επίδρασή τους ξεθωριάσει. Το εμβόλιο του Imperial μπορεί να επαναληφθεί όσες φορές χρειαστεί.
Σημαίνει αυτό ότι είναι και καλύτερο; «Πιστεύω ότι είναι δύσκολο να κρίνει κανείς», υποστηρίζει ο Σάτοκ. «Αν ισχύει και στους ανθρώπους αυτό που βλέπουμε στα ζώα, θα έχουμε άλλης ποιότητας απόκριση του ανοσοποιητικού. Αυτό πιθανότατα συμβαίνει επειδή αποτελείται από δύο δόσεις. Πιστεύω ότι θα δούμε μεγαλύτερες ποσότητες αντισωμάτων. Το κατά πόσον αυτό θα προκαλέσει διαφορές στο βαθμό προστασίας παραμένει άγνωστο».
Το Imperial θα ξεκινήσει τις δοκιμές σε ανθρώπους τον Οκτώβριο. «Κατά πάσα πιθανότητα θα ξέρουμε αν είναι αποτελεσματικό μέχρι το τέλος της χρονιάς».
Με το βλέμμα στραμμένο στο μέλλον
Ελπίδα του Σάτοκ είναι ότι αν το εμβόλιο για τον κοροναϊό πετύχει, θα ανοίξει το δρόμο για πολλά ακόμη στο μέλλον. «Στην επόμενη πανδημία, ελπίζουμε ότι αυτή η τεχνολογία θα είναι έτοιμη να παραχθεί σε πολλές περιοχές του πλανήτη, πολύ, μα πολύ ταχύτερα. Βρισκόμαστε σε ένα μεταβατικό στάδιο. Σε πέντε χρόνια, πιθανότατα όλοι θα χρησιμοποιούν τέτοιου είδους τεχνολογίες για ξεσπάσματα παθογόνων».
Είναι γρήγορο και είναι φθηνό. Αν λειτουργήσει, ίσως χρησιμοποιηθεί και για εμβόλια που δεν αφορούν μόνο ξεσπάσματα ιών, αλλά και ενδημικές ασθένειες που πλήττουν τις φτωχότερες χώρες και για τις οποίες συνήθως αδιαφορούν οι φαρμακευτικές εταιρείες, από τη στιγμή που δεν υπάρχουν περιθώρια κέρδους.
Πηγή: www.theguardian.com







